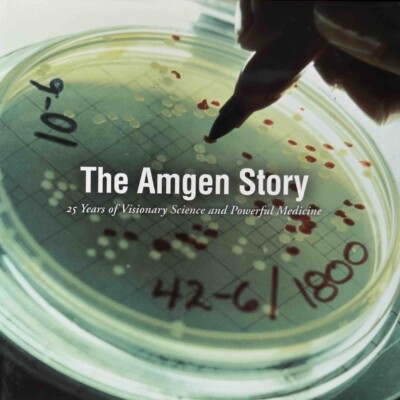

incomparable books
Want to publish your corporate history?
We’ve got you covered!
Like other publishers of commemorative corporate, institutional, and academic histories, Incomparable Books manages the entire process from the initial concept to distribution.
The difference is the superior quality of our writing, editing, and design. We prioritize artistic merit and literary excellence, striving for the highest standard of creativity to capture your story in the most compelling manner.
Our company is managed directly by the author, editor, and designer, enabling personalized, innovative, and hands-on client services.
By focusing on roles that directly support the creative process—and book distribution, if needed—we offer an economic value proposition that is second to none.
trusted by the best













incomparable team
Book Writing, Editing, and Design
Russ Banham
Author and President
Russ is among the world’s foremost corporate historians and business journalists. His 35 books comprise the anniversary histories of Ford, Boeing, Airstream, Bosch, Coors, New York Life, and many other large, midsized, and smaller enterprises that are publicly traded, private, or family owned. Nominated for a Pulitzer Prize, Russ has written thousands of feature articles for Forbes, Chief Executive, The Economist, Financial Times, Euromoney, Fortune, Inc., CFO, Corporate Board Member, The Journal of Commerce, and The Wall Street Journal.
Betsy Holt
Creative Director
Betsy has written, edited, and/or project managed nearly 100 nonfiction books, many of them award winning, for high-profile corporate clients, nonprofits, major cultural attractions, and academic institutions. As an editor, Betsy helps ensure each client’s unique voice comes through in their story. She has edited many books written by Russ Banham, including the anniversary histories of Harvard Business School, Bosch, Hawaiian Airlines, and Harbor Foods as well as the two editions of The Fight for Fairfax.
Vicky Vaughn Shea
Design Director
Vicky has designed and laid out hundreds of books over the past 25 years. Although Vicky specializes in designing nonfiction corporate history books, she has also designed cookbooks, guidebooks, gardening and home improvement books, travel books, gift books, and children’s books. Many corporate history books that Vicky designed were written by Russ Banham and/or edited by Betsy Holt, including the anniversary histories of Harvard Business School, Belden, Progress Rail, Mississippi Power Company, and the American Council on Education.